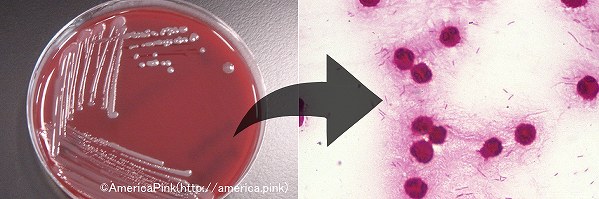

夫の庭作業中に野良猫の被害にあった可能性も
 https://headlines.yahoo.co.jp/hl?a=20171109-00000006-rkkv-l43
https://headlines.yahoo.co.jp/hl?a=20171109-00000006-rkkv-l4344:名無しさん@1周年 : 2017/11/09(木)12:35:08.31 ID: QIZOnYNA0.net
家族は寝たきりの人を放置して外出?
色々と闇が深そう
116:名無しさん@1周年 : 2017/11/09(木)12:46:45.73 ID: wIdWpEmD0.nethttp://ai.2ch.sc/test/read.cgi/newsplus/1510198000/
>>44
ローカルニュースでやってたけど夫は庭作業してて部屋に戻ったら
寝たきりの妻が顔を切り刻まれているのを発見って流れだったよ
夫は耳が遠くて警察に通報出来ない(一応したのかもしれないけど会話出来なかったのかも)
→世話になってるヘルパーさんに連絡して警察に通報って流れだった
顔の傷は猫に引っ掻かれたような規則性のある傷だったらしい
「野良猫の殺人未遂事件」マスメディアによるニュース報道に疑問の声も
 https://xn--q9j2c601vh3refa.net/color/q-a.html
https://xn--q9j2c601vh3refa.net/color/q-a.html
熊本でおきた82歳の寝たきり女性殺人未遂事件で野良猫が犯人か??ってそんなニュースする意味あるんか⁇
— Audemars@Hiko (@HikomanJapan14) 2017年11月9日
ニュースで85歳ぐらいのおばあちゃんが20ヵ所ぐらい切り傷があり、殺人未遂事件として捜査した、と聞きこれはまた大事件か?と思っていたら、捜査した結果どうやら野良猫に引っ掛かれたという落ちだった。当事者や周りの方はそりゃ心配されただろうが、これはニュースで流す事なのか?疑問
— マユ (@maulovefatcat) 2017年11月9日
犬猫による代表的な感染症など
猫ひっかき病
 https://detail.chiebukuro.yahoo.co.jp/qa/question_detail/q1283151537
https://detail.chiebukuro.yahoo.co.jp/qa/question_detail/q1283151537猫ひっかき病(ねこひっかきびょう、英語: Cat scratch disease;CSD)はバルトネラ・ヘンセラ菌によって引き起こされる、リンパ節の炎症を主体とした感染症。人獣共通感染症の一つである。
症状
受傷部が数日から4週間程の度潜伏期間後に虫刺されの様に赤く腫れる。典型的には、疼痛のあるリンパ節腫脹、37℃程度の発熱、倦怠感、関節痛など。まれに重症化する事があり、肝臓や脾臓の多発性結節性病変、肺炎、脳炎、心内膜炎、肉芽腫、急性脳症などの発症例が報告されている。
腫脹したリンパ節は多くの場合痛みを伴い、体表に近いリンパ節腫張では皮膚の発赤や熱感を伴うこともある。ほとんどの人で発熱が長く続き、嘔気等も出現する。
特に治療を行わなくても、自然に治癒することも多い。しかし治癒するまでに数週間、場合によっては数ヶ月もかかることがある。
肝膿瘍を合併することがあり、免疫不全の人や、免疫能力の落ちた高齢者では、重症化して麻痺や脊髄障害に至るものもある。
https://ja.wikipedia.org/wiki/猫ひっかき病
パスツレラ症
 http://lorettaloretta.com/2014/11/12137/
http://lorettaloretta.com/2014/11/12137/パスツレラ症(パスツレラしょう、英: pasteurellosis)は、パスツレラ属(Pasteurella)菌を原因菌とする日和見感染症。
疫学
イエネコの口腔には、約95%、爪には70%、イヌの口腔には、約75%の確率でパスツレラ属菌が常在菌として存在する。つまり、人獣共通感染症の様相を呈している。
殆どが、咬傷あるいは掻傷により感染する。まれに経気道感染や飛沫感染などにより呼吸器系の疾患を起こす事がある。低免疫状態からの日和見感染、糖尿病、アルコール性肝障害の罹患者は重症化しやすい。鶏肉が原因となった疑いのある食中毒症状の報告もある。
症状
・犬、猫では一般に無症状。
・ウシの出血性敗血症。
・ヒトでは一般に無症状か軽症。咬傷箇所の発赤・腫脹・化膿(蜂巣炎)、気管支炎・肺炎などの呼吸器疾患、まれに髄膜炎。
咬傷、掻傷の約30分 – 数時間後に激痛を伴う腫脹と精液様の臭いのする浸出液が排液される。
https://ja.wikipedia.org/wiki/パスツレラ症
カプノサイトファーガ・カニモルサス感染症
http://www.konekono-heya.com/byouki/zoonosis/capno.html
http://www.konekono-heya.com/byouki/zoonosis/capno.htmlカプノサイトファーガ・カニモルサス感染症
主にイヌやネコなどによる咬傷・掻傷から感染し、発熱、倦怠感、腹痛、吐き気、頭痛などの症状を伴う。重症例では劇症の敗血症や髄膜炎を引き起こし、播種性血管内凝固症候群(DIC)や、敗血性ショック、多臓器不全に進行して死に至る事がある。
脾臓摘出者がかかり易く、免疫機能の低下(アルコール中毒、糖尿病などの慢性疾患、免疫異常疾患、悪性腫瘍にかかっている方、高齢者など)が重症化に繋がりやすい。
https://ja.wikipedia.org/wiki/カプノサイトファーガ・カニモルサス
少し犬猫による感染症について調べただけでもこれだけたくさんの病気がありました。中には重症や死に至る恐れもある物もあるので、ただ「イヌやネコに引っ掻かれただけだから」と甘く見てはいけませんよね。
狂犬病などは現在でもアフリカ・アジア地域で年間5万人の死者が出ているそうです。wikipediaによると狂犬病は「最も致死率が高い病気」として後天性免疫不全症候群(エイズ)と共に、ギネス世界記録に記録されているとの事。
ネット上の反応
2chでの反応
4:名無しさん@1周年 : 2017/11/09(木)12:27:51.64 ID: paNmcBH60.net
ネコとかってライオンとかトラとか仲間だからな
まめ知識な7:名無しさん@1周年 : 2017/11/09(木)12:28:10.28 ID: tfx9A0nM0.net
猫身を襲われたのか10:名無しさん@1周年 : 2017/11/09(木)12:29:22.20 ID: lHhh6HsR0.net
爪研ぎでもしたんかいな328:名無しさん@1周年 : 2017/11/09(木)13:53:49.69 ID: rxbYnkrn0.net
>>10
おてもそう思った
不謹慎だけどw13:名無しさん@1周年 : 2017/11/09(木)12:30:05.29 ID: nfeGpoW+0.net
きゃっと驚いただろうな14:名無しさん@1周年 : 2017/11/09(木)12:30:11.94 ID: GtyDGJUj0.net
猫に事情聴取するのか148:名無しさん@1周年 : 2017/11/09(木)12:53:39.59 ID: SD1IAjEy0.net
>>14
にゃーん(解せぬ)16:名無しさん@1周年 : 2017/11/09(木)12:30:27.91 ID: E3SmcfFl0.net
猫って時々すごい事するからな
俺もご飯皿が空っぽなのに気づかずお昼寝してる時
頭を齧られた事ある
しばらくかさぶた出来てて20:名無しさん@1周年 : 2017/11/09(木)12:31:05.84 ID: 2manfCqC0.net
どういう事だ
この家の飼い猫の犯行か
野良猫が家宅侵入しての犯行なのかわからん430:名無しさん@1周年 : 2017/11/09(木)14:40:16.76 ID: RGhKpv6Q0.net
>>20
野良を自宅に入れて半飼い猫って感じにしてたようだよ454:名無しさん@1周年 : 2017/11/09(木)14:55:53.60 ID: rvv/9Ry10.net
>>430
ふーん
やっぱりこの寝たきりの女性が猫に
獲物と勘違いされたのか
猫自身を脅かしそうな何かの挙動をしたのか
どっちかだと思うな
寝たきりになってるくらいだから、動かせるのは腕や頭くらいだと思うんだけど
女性が何かの痛みで唸ったりしたのかな?敵と勘違いされるような…21:名無しさん@1周年 : 2017/11/09(木)12:31:17.59 ID: 4JxF6i6q0.net
飼いネコは肉球で叩いてくるが
野良猫は爪だして引っかいてくるからな91:名無しさん@1周年 : 2017/11/09(木)12:43:07.60 ID: Gwsg2T5C0.net
>>21
ペシペシ叩いてくるよな
お腹触ろうとすると爪使わずに掴んで離そうとしてくる
それでも無理やり触ろうとすると引っかかれる
爪が凶器になること知ってんだろうなあ162:名無しさん@1周年 : 2017/11/09(木)12:56:20.85 ID: Yt+fX3sC0.net
>>21
ふざけて頭突き出すと爪しまって前足でパチーンしてくるわ。車のタイヤで爪研ぎしたり、車のフロントガラス足跡だらけにしてご満悦してるわ。163:名無しさん@1周年 : 2017/11/09(木)12:56:45.35 ID: RGh0LIJa0.net
>>22
これを見に来た271:名無しさん@1周年 : 2017/11/09(木)13:30:37.08 ID: ar+f2hpG0.net
>>22
カラーポイントでカワイイんだが
見るたびじわじわ来るよな、ハヤシww716:名無しさん@1周年 : 2017/11/09(木)17:44:58.84 ID: IIJYadhq0.net
>>22
これリアルタイムで見た時笑った24:名無しさん@1周年 : 2017/11/09(木)12:31:31.07 ID: AELLUfbv0.net
ねこ、こんなことするんだ28:名無しさん@1周年 : 2017/11/09(木)12:32:13.82 ID: Chqx8En40.net
なぜ自分で通報せず訪問看護師?31:名無しさん@1周年 : 2017/11/09(木)12:32:46.31 ID: +KECgGps0.net
猫の恩返し123:名無しさん@1周年 : 2017/11/09(木)12:47:56.67 ID: 6HZbhkqf0.net
>>31
この場合、猫の意趣返しだな32:名無しさん@1周年 : 2017/11/09(木)12:32:52.30 ID: kUSHxFw70.net
多分だが、
女性は何らかの発病をして重篤な状態になった。
ネコは、ご飯を貰おうと鳴いたり舐めたりしたが、応答がない。
で、噛んだり引っかいたりして起こそうとおもった(体温があれば、寝てると勘違いする)。
↓
家族が血だらけの女性を発見
↓
ネコの爪から血液が!
てな、流れだとおもう。
35:名無しさん@1周年 : 2017/11/09(木)12:33:49.60 ID: c1cZutP8O.net
帰宅した家族らってどういうことだ
寝たきりの人がいるのに戸締まりをしないで猫が入ってこられる状態だったのかな
この寒いのに窓開けっ放しってこと?
猫をわざと閉じ込めてたりして36:名無しさん@1周年 : 2017/11/09(木)12:33:57.77 ID: wc6ps9+C0.net
寝てる時、最初は肉球でソフトタッチだけれど、無視してたらだんだん爪立ててくるんよ38:名無しさん@1周年 : 2017/11/09(木)12:34:29.01 ID: voF9KhUeO.net
爪切ってねーね?ズボラな家族だなと思ったら野良か
餌与えてる奴が犯人猫の親分39:名無しさん@1周年 : 2017/11/09(木)12:34:41.49 ID: 9H5FcVCa0.net
猫の恩返しだ853:名無しさん@1周年 : 2017/11/09(木)19:18:35.89 ID: OP18ZYe40.net
>>39
猫のお礼参りだ45:名無しさん@1周年 : 2017/11/09(木)12:35:14.60 ID: T3UhXyS00.net
猫は飼い主が病気とかで起き上がれなくなって
餌を貰えなくなると飢えて飼い主を襲って食うからな
今までこういう事件は何回もある46:名無しさん@1周年 : 2017/11/09(木)12:35:21.98 ID: owgXg2rK0.net
猫は何のためにこんな事したんだ?エサだと思ったとか?81:名無しさん@1周年 : 2017/11/09(木)12:41:21.41 ID: njNonKuj0.net
>>46
エサ寄越せって起こそうとした50:名無しさん@1周年 : 2017/11/09(木)12:35:37.98 ID: sR+0++8q0.net
エサあげ忘れたんだろうな
なんとか起こしてエサもらおうとしたんだろ52:名無しさん@1周年 : 2017/11/09(木)12:35:58.59 ID: elFxU+YC0.net
被害女性が死にかけてたから、異常を感じた猫がひっかいて一命をとりとめた…と言う可能性はないか?66:名無しさん@1周年 : 2017/11/09(木)12:38:36.12 ID: HV7xnKNj0.net
世話してた野良か
餌が欲しくて家宅侵入・誰も居ないので寝たきり婆さんに接近
婆さんにねだるが当然餌をやれない状態なので婆さんに八つ当たり犯行?
もしくは婆さんが何か猫を刺激するようなことをした?
あとは婆さんは何もしてないが口から食べ物の匂いがしたからこじ開けようとしたとか75:名無しさん@1周年 : 2017/11/09(木)12:40:59.95 ID: zBxDsTvf0.net
自宅に侵入した野良猫に威嚇されたことがある。79:名無しさん@1周年 : 2017/11/09(木)12:41:13.04 ID: yqBbWOdD0.net
寝たきりだからって重傷負わせるほど引っ掻くものなの?
家猫じゃなくて野良猫だからかな115:名無しさん@1周年 : 2017/11/09(木)12:46:38.35 ID: zBxDsTvf0.net
>>79
野良子猫も威嚇してくる88:名無しさん@1周年 : 2017/11/09(木)12:42:40.06 ID: Hb+H8QBp0.net
そのうち子供にも噛み付くようになる
昭和の野良猫はそうだった99:名無しさん@1周年 : 2017/11/09(木)12:44:19.83 ID: HV7xnKNj0.net
>>88
猫は基本的に子どもが嫌いだから手出ししなければ噛みつかれることはない
まあごくまれに襲ってくるのも居るけど本当に稀93:名無しさん@1周年 : 2017/11/09(木)12:43:14.28 ID: pSoSFTIX0.net
猫とライオンの性格は同じらしいよ
大型の犬っているけど、大型の猫ってペットにはいないよね
制御できないから109:名無しさん@1周年 : 2017/11/09(木)12:45:40.84 ID: r/ND1JI00.net
>>93
どんなに飼い主に甘えてる最中でもいきなり引っ掻いてくるもんな。
大型猫死ぬわ。95:名無しさん@1周年 : 2017/11/09(木)12:43:49.54 ID: E6UaS6WM0.net
たぶん女性の体内で血が作られた時に
同時にネコの爪の先にも現れただけ
これは量子力学では正しい
ネコの無実は科学的に証明された100:名無しさん@1周年 : 2017/11/09(木)12:44:28.92 ID: BhodzcIz0.net
昔あった事件
あるアパートで一人暮らしの老人の遺体が発見された
老人の性器は切り取られており、当初は異常者による犯行と思われたが
真相は脳卒中で倒れて動けなくなった飼い主の性器を飢えた飼い猫が食ったことによる失血死だった107:名無しさん@1周年 : 2017/11/09(木)12:45:21.78 ID: +unEJGFL0.net
猫は基本、重傷になるほど人間を襲わないよ
工作をした人間がいないか調べたほうがいい113:名無しさん@1周年 : 2017/11/09(木)12:46:27.90 ID: MFWoJR0O0.net
顔にクモでもついてたのか114:名無しさん@1周年 : 2017/11/09(木)12:46:37.02 ID: pST1sUGG0.net
寝たきりなのになんで野良猫に引っかかれるの?124:名無しさん@1周年 : 2017/11/09(木)12:48:14.61 ID: aclIqSl60.net
>>114
家族が野良猫に餌付けしてたんだろうね125:名無しさん@1周年 : 2017/11/09(木)12:48:20.18 ID: wfXUJ8gk0.net
ウルヴァリン最低だな引用元:【熊本】ネコの犯行か 寝たきり女性が重傷、野良猫の爪から血液反応126:名無しさん@1周年 : 2017/11/09(木)12:48:27.79 ID: lcg0a2hp0.net
これは猫に見せかけた完全犯罪だよ
twitterでの反応
そういえば、なんかのニュースで、寝たきりの老人が顔に怪我しててってやつ。殺人未遂とかで捜査してるけど野良猫の爪から老人のDNAかなにか見つかったとかの。
— 超うるせぇトリ コト ちゅん (@chun__sama) 2017年11月9日
「その家が世話をしていた野良猫」って出てくるんだけど、飼わずに世話してるの?野良猫?飼い猫?無責任でない?(餌やりさん否定派)
“殺人未遂事件” 犯人は野良猫の可能性
— オヤス。 (@oyas_is) 2017年11月9日
ってなかなかパワーのあるワードだな。
ほんと野良猫で殺人未遂て・・・。うそやん・・・・。
— ちゃんと小説♪ @♰湿布最高 (@x83z4w) 2017年11月9日
野良猫が殺人未遂かよ
— きゅぴー (@WingEXE) 2017年11月9日
殺人云々の犯人が野良猫かもしれないって日本のそうゆう所好き
— crazy sakamoto night (@sakamonn3) 2017年11月9日
寝たきりの高齢者の患者さんが足の指をネズミにかじられてたとかは噂話で聞いたことはあったけど、殺人未遂にされる野良猫は凄いなRT
— おーわだ (@oowadajyoumu) 2017年11月9日
野良猫が殺人未遂だとさ?
— キャベツ? (@kyabetsu10) 2017年11月9日
病む。おばちゃんからメール。「あたしな、野良猫問題でいつかここで殺人事件起こると思うわ」
— akio1205 (@akioooo1205) 2017年11月9日
寝たきり女性が顔中傷だらけの殺人未遂事件がまさかの野良猫からの襲撃かもしれないってそれはそれで怖いな、、、
— 不知火 (@SHlRANUI) 2017年11月9日
ニュース見てたけど。
— みたらし?無言お迎え中 (@mitarasisousaku) 2017年11月9日
野良猫の仕業???ネコがひっかいた???前「殺人未遂事件」って……
殺人未遂事件の犯人が野良猫w警察は何やってんだかな(^-^;)
— たけちゃん@岡田愛原理主義 (@takechan0908) 2017年11月9日
殺人未遂事件の犯人が判明!!
— 雨蛙@クィーンマッシュ・アスカ改 (@qg4b755x) 2017年11月9日
野良猫の仕業でした(笑)
安定の田舎でわらけたwww
御船の殺人未遂の犯人が
— shinji♯6熊本四池 (@shinji22190672) 2017年11月8日
猫の可能性だと、、、
野良猫が出入りしてたと
書いてはあったが
真相が気になるところ。#熊本日日新聞
寝たきり女性のニュース、野良猫のしわざってほぼ確定っぽいけど家の中で寝てる女性に猫が何度も引っ掻くって気が触るような事したんだろうか(; ̄ェ ̄)何度も引っ掻くってよっぽどだよね...うーん...
— chizuru / イラストレーター (@chibiyui) 2017年11月9日
まとめ
猫にとっては愛情表現のつもりが、このような殺人未遂事件として捜査する事件にまで発展してしまい、少々気の毒のような気もします。ひとまず寝たきりの女性に命の問題は無いようで 何よりでした。
もし仮に猫が犯人だったと断定されても、女性の家族が世話をしていたとの事なので、どうか猫に罪は問わないで欲しいと願います。
最後までお読み頂きありがとうございました。
- 出会い系バーってどんなお店?前川事務次官の貧困調査の実態とは…出会い喫茶や出会いカフェの利用者は割り切りや援助交際が目的?気になる噂まとめ
- 自民党の豊田真由子議員、傷害罪で逮捕の可能性も?秘書への暴行や「ハゲ発言」を含む暴言を録音した音声が流出し炎上…本人は離党届を提出し入院
- 畷優奈(なわてゆうな)の顔画像、写真やFacebookは?関学の彼氏を殺害未遂で逮捕…甲山落語研究会での高座名は五月家かのこ?事件の情報まとめ
- 牛乳石鹸のCM「さ、洗い流そ。」に批判殺到!「もう買わない」「ただただ不快」YouTubeで公開され2ちゃんねるでは「炎上商法」と話題に…まとめ
- 世界地図から日本を韓国が消した理由とは?平昌(ピョンチャン)オリンピック公式HPの世界地図上から日本列島が一時削除されネット上で話題に


























